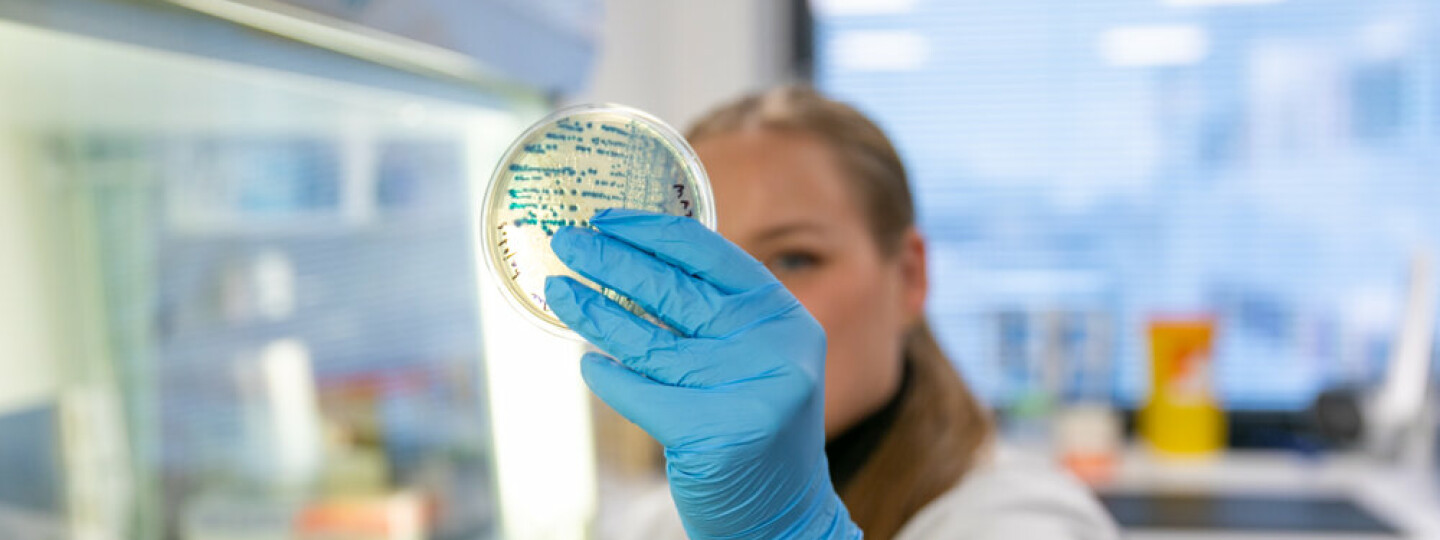

Nutrition and Food Research Center is a unique combination of nutrition and food science expertise as part of medical sciences. Even internationally there are only few such units enabling close dialogue and collaboration between food, health and medical sciences. Our center possesses clinical research facilities, sensory laboratory and coordinates Flavoria® Research Platform enabling in depth studies on complex relationship of nutrition and healthy, sustainable food choices.
Mission
Our mission is to excel in researching the complex interplay between food, human metabolism and health, and to disseminate and apply the knowledge accrued on well-being of people and nature.
Vision
We are at the forefront in international, multidisciplinary food and nutrition research which we conduct with experts from different scientific disciplines. We promote human health over generations.
Strategy
We specialize in executing research projects that explore the characteristics of food, its interactions within the human body, as well as the aspects of food-related experiences and behaviors. We are interested especially in sustainable food choices, dietary intake, gut microbiota and subsequent metabolic and clinical health impacts throughout the human lifecycle.
We develop and apply methods for research and assessment of dietary intake, food behavior and human nutritional status and metabolism.
We actively collaborate with national and international actors from different scientific fields who share our mission. We develop and coordinate the Flavoria® Research Platform which consists of a research restaurant, a cafeteria and a multisensory space.
We provide evidence-based education and training for various groups, including undergraduate and postgraduate students, and enable continuous learning.
We apply research findings for the benefit of people, communities and industry.
Values
Our values are creativity, openness, ethical principles, critical thinking, and strong community.